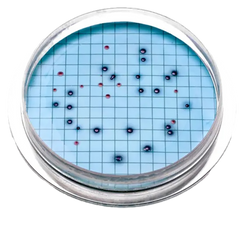
M-Coliblue24

SUBSCRIBE TO OUR NEWSLETTER
Register now to get updates on promotions and coupons.
The site owner may have set restrictions that prevent you from accessing the site. Please contact the site owner for access.

Estimated Delivery
Jun 05 - Jun 12
Couldn't load pickup availability
Free standard shipping on orders over $50